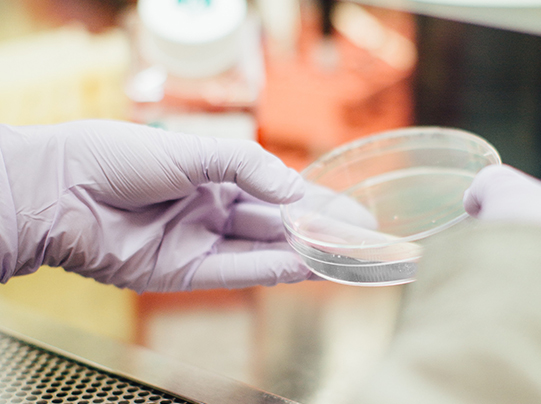

-

- Why Writebest
-
Product
-
Writing
- Wall Mounted Board
- Mobile Board
- Flip Chart
- Board System
- Menu & Information Board
- Junior Range
-
Featured products
Range
-
Notice
- Notice boards
- Display panels
Range
Featured products
-
Design & Presentation
Featured products
-
Display
Featured products
-
Organisation
Featured products
-
Others
- Accessories
- Tarifold
Range
Featured products
- All Products
- Back
Categories
-
Writing
-
Blog
-
Custom-Made Products
All our products are highly customisable
Want a whiteboard with special shape a couple of office panels with specific colours to suit your interior design? We've got you covered.
Know how -
e³ CeramicSteel & Hygienic
The bacteria & viruses resistant writing surfaces
The e3 CeramicSteel is best known for its anti-bacteria feature. The writing surface is also 99% recyclable which makes it super eco-friendly!
Read More -
Inspiration
-
Education
-
Stimulate learning in a classroom
Whiteboards and chalkboards create conducive spaces to learn and educate. This is just one of the many benefits writing boards bring to the classroom. See our range of writing boards designed for all learning spaces.
View More
-
-
Workspace
-
Achieve a productive brainstorming session
You need an ideal space and also the right tools to ensure your team feels comfortable and confident to share their ideas. See our range of writing boards specially designed for all types of working spaces.
View More
-
-
Design
-
Made for architects and interior designers
We understand tools are important when it comes to creating and drafting, especially for architects. We also provide custom-made products to suit any interior style, so that you don’t have to compromise aesthetics for functionality.
View More
-
-
Medical
-
Minimise the spreading of bacteria and viruses
In a place that provides healthcare to the public, environmental health and cleanliness are of utmost importance. We have boards designed to keep both doctors and patients safer and off contact with bacteria and viruses.
View More
-
-
Retail
-
Inject style and organisation into your shop
A good vibe and an organised space are essentials when it comes to driving traffic into your shop and attracting happy customers. Get your shop in style with our products specially designed for restaurants, cafes and retails shops.
View More
-
-
Public spaces
-
Keep crowd in control with ease
It is possible to keep the public safe, organised and moving efficiently with our products specially designed for the public. Our sturdy signages help reduce confusion and promise a pleasurable experience for your customers.
View More
-
Inspiration
-
Education
-
Eco Technologies
We implement eco-technologies in our products
We fully embrace the use of environmentally friendly materials. Learn more about the eco-friendly technologies we used while designing our products.
Know how - All articles
- Back
Articles
-
Custom-Made Products
- About
-
Location
-
Selangor (HQ)
WriteBest HQ - Hulu Langat, Selangor
Our headquarter and a 250,000 sq ft manufacturing plant is in the beautiful mountains of
See location
Hulu Langat. -
Johor
WriteBest - Johor branch - Johor Bahru, Johor
A key hub for logistics and distribution, supporting faster deliveries and seamless operations across the southern region.
See location -
Sabah
WriteBest - Sabah branch - Kota Kinabalu, Sabah
Equipped to serve East Malaysia with localised support, ensuring better accessibility to our products and services.
See location -
Sarawak
WriteBest - Sarawak branch - Sibu, Sarawak
Focused on efficient supply and service, strengthening connections with businesses across Sarawak and beyond.
See location - Back
Malaysia
-
Selangor (HQ)
- Contact